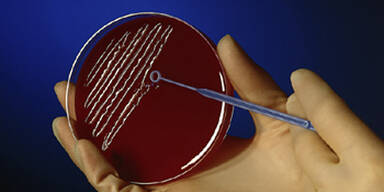
bakterien petrischale

Die Tuberkulose-Fälle häufen sich: Ein Lehrer starb, 13 Schüler wurden erfolgreich mit Antibiotika behandelt.
Nach der Häufung von Tuberkulosefällen in diesem Sommer in vier Zürcher Schulhäusern prüft die Schulbehörde in der Schweizer Wirtschaftsmetropole jetzt eine Ausweitung von Kontrollen. Am Donnerstag war bekannt geworden, dass ein Lehrer an Tuberkulose gestorben ist. 13 Züricher Schüler seien im Sommer mit Tuberkulose in Kontakt gekommen, vier galten als infiziert.
Die infizierten Schüler wurden erfolgreich mit Antibiotika behandelt, teilte Daniel Frey, Direktor des Schulgesundheitsdienstes, mit. Alle anderen Schüler habe man vorsorglich Antibiotika verabreicht. Auch alle Lehrer im Umkreis des verstorbenen Lehrers seien getestet worden, bei drei habe sich ein Verdacht auf Tbc-Infektion gezeigt.
Fälle auch in anderen Schulen
Der verstorbene 47-jährige Lehrer an der Schule Zürich-Wiedikon hatte neun Schüler mit Tuberkulose in Kontakt gebracht. Die wenigen Fälle in den drei anderen Schulhäusern hätten keinen Zusammenhang mit diesem Fall gehabt, präzisierte Frey. Er sprach von einer zufälligen Häufung im laufenden Jahr. 2004 gab es nur einen Tuberkulose-Fall in Zürich, 2005 gar keinen.
Der verstorbene Lehrer habe sich nicht im Ausland angesteckt, sagte Otto Brändli, Chefarzt an der Zürcher Höhenklinik Wald, gegenüber "Schweiz aktuell" von SF DRS. Auch habe er sich nicht in letzter Zeit angesteckt."In seiner Kindheit hat es in der Familie Tuberkulosefälle gegeben."
Kontrollen wurden eingestellt
Laut Frey wird nach den Ereignissen vom Sommer die Lage jetzt genau beobachtet. Aufgrund des starken Rückgangs von Tuberkulose seien die aufwendigen Kontrollen in den Zürcher Schulen in den 1990er-Jahren eingestellt worden.
Eventuell sollen künftig wieder mehr Untersuchungen an Schülerinnen und Schülern gemacht werden. Ein gewisses Risiko stellen laut Frey auch Kinder aus Ländern dar, wo Tuberkulose noch stärker verbreitet ist.